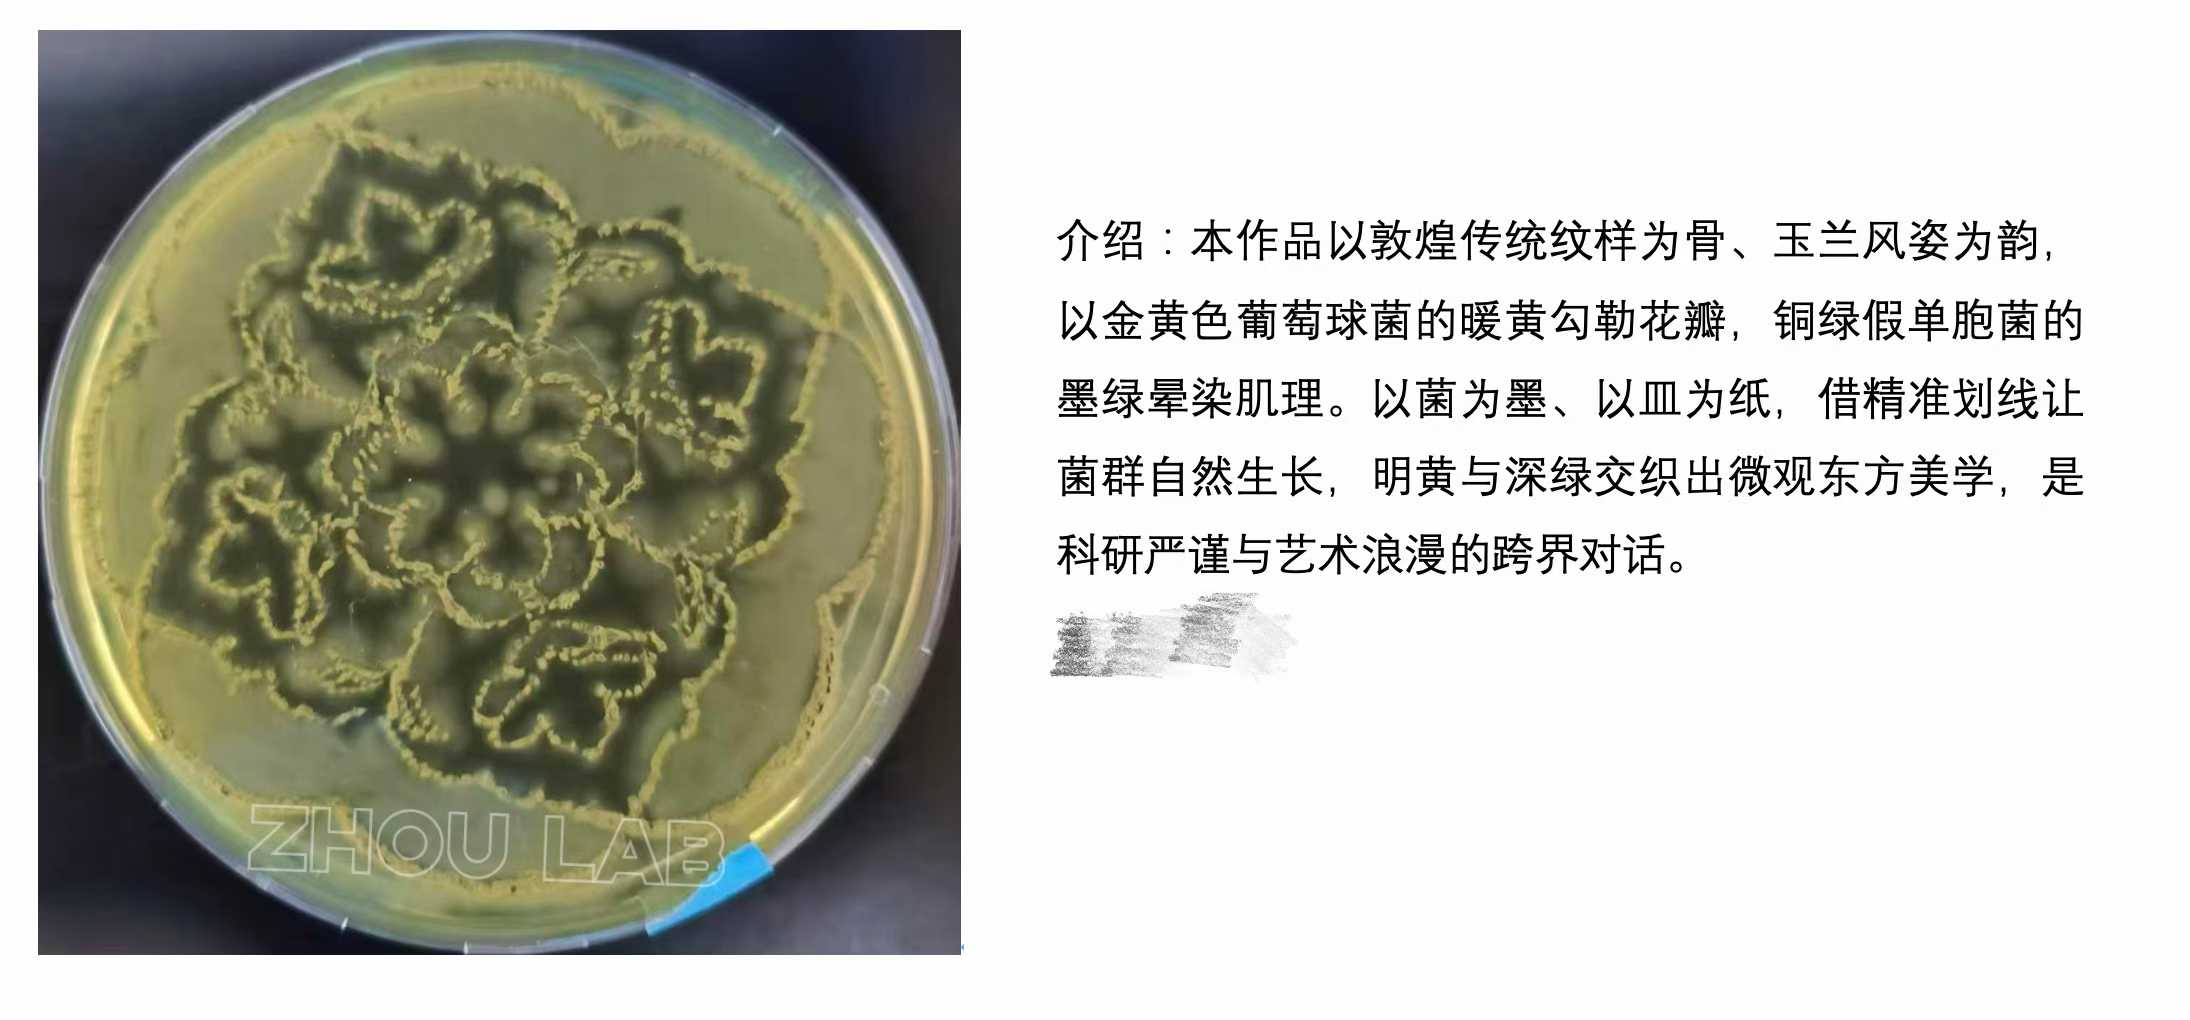

+
周翌丹
职务:副教授
主要任职:
个人信息
- 副教授
- 教师拼音名称:ZHOU YIDAN
- 电子邮箱:yzhou12@whu.edu.cn
- 所在单位:公共卫生学院
- 职务:副教授
- 学历:博士研究生毕业
- 性别:女
- 职称:副教授
- 在职信息:在职
- 毕业院校:美国伊利诺伊大学香槟分校
- 学科:微生物学
流行病与卫生统计学
曾获荣誉:
- 湖北省青年拔尖人才
- 武汉大学青年全球合作大使
- 湖北省青年晨光托举计划
- 武汉英才
- Mr. Chinoree T. and Mrs. Kimiyo Enta Fellowship
- 国家奖学金
- 校长奖学金

手机版